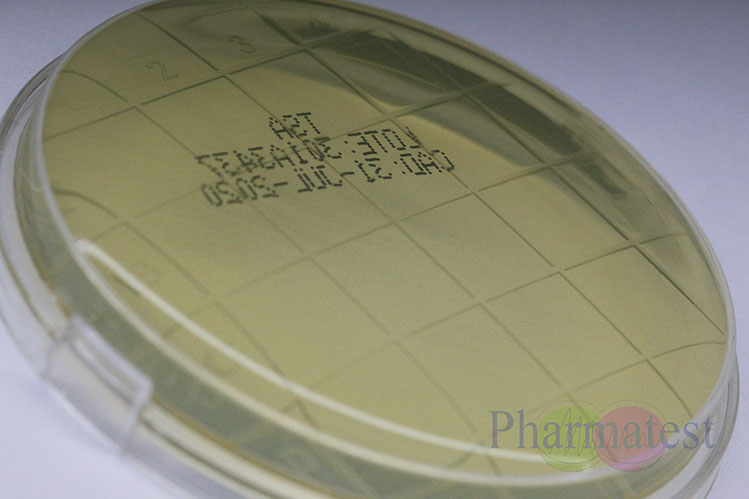
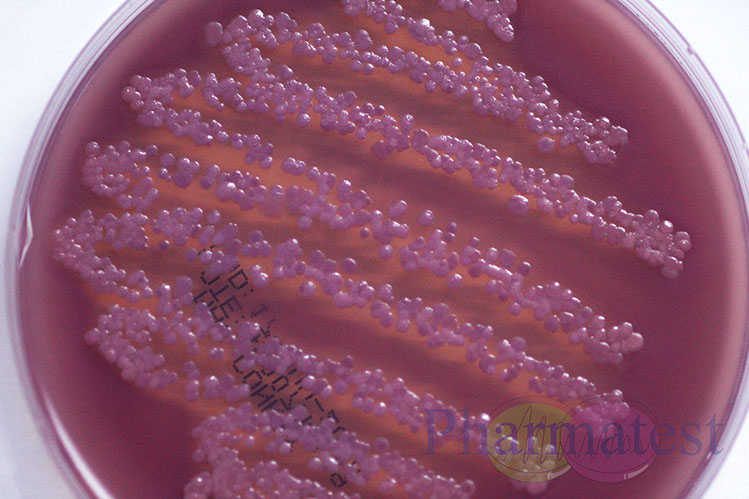

Todos nuestros productos son elaborados con los mas altos estándares de calidad y nuestro personal esta calificado para cumplir con los requerimientos que necesitan.

Placas de contacto tipo RODAC
Petri 90 mm Métodos Estándar
Placa de contacto tipo RODAC TSA
Petri 90 mm Neutralizante
Placa de contacto tipo RODAC vacía
Placas Petri 90 mm
Placas de contacto tipo RODAC vacías
Crecimiento en placa Petri 90 mm
Tubo Caldo Tioglicolato
Tubo solución salina
Llenado de placas
<
11 - 11
>






